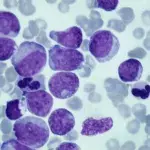
Default image

Staples that make the British diet are fuelling heart disease, according to experts
A new study conducted by the University of Oxford has found that diet staples in British households, like bread and butter, are fuelling lethal heart diseases.
White bread, butter, jam and chocolate—British diet staples—have been criticised by medical experts for being conducive to deadly heart diseases.
Foods that can kill
Researchers from the University of Oxford have pointed out that the high caloric, fatty and sweet content coupled with low amounts of fibre in such foods are responsible for fuelling heart disease in the UK. A study was conducted analysing what 116,806 individuals in the UK consumed on a weekly basis over the span of five years.
Over the course of the study, 4,245 participants developed cardiovascular diseases of which 838 suffered from either a fatal heart attack or stroke. Dr Carmen Piernas, who worked on the study, explained:
The most common dietary guidelines are based on the nutrients found in foods rather than foods themselves and this can be confusing for the public. Our findings help identify specific foods and beverages that are commonly eaten in Britain and that may increase the risk of cardiovascular disease and mortality.
And added:
Cardiovascular disease is one of the main causes of death and disability in the UK and poor diet is a major contributor to this.
Some of the foods that were particularly concerning due to their prevalence in British diets include:
- English breakfasts
- Fish and chips
- Fast foods
- chocolate and sweets
- artificially sweetened fruit juices
Fatty and sweet foods increase risk by 40%
According to the study, two distinct patterns of consumed types of foods were found to have a direct correlation with those who developed heart problems: fatty and sugary favourites.
The study found that those whose diets incorporated heavy amounts of either one of the two patterns were 40% more at risk of developing serious cardiovascular diseases. Dr. Piernas said:
Our research suggests that eating less chocolate, confectionery, butter, low-fibre bread, sugar-sweetened beverages, fruit juice, table sugar and preserves could be associated with a lower risk of cardiovascular disease or death during middle-age. The findings of this study could be used to create food-based dietary advice that could help people eat more healthily and reduce their risk of cardiovascular disease.